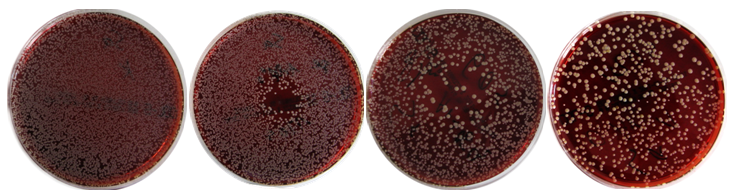

[Eine Pilotstudie zum Einfluss der Modifikation der Trägergase und der Plasmaapplikation (offen bzw. abgeschirmt) auf den antimikrobiellen Effekt von physikalischem Plasma gegen Pseudomonas aeruginosa und Staphylococcus aureus]
Rutger Matthes 1Sander Bekeschus 2,3
Claudia Bender 1
Ina Koban 4
Nils-Olaf Hübner 1
Axel Kramer 1
1 Institute for Hygiene and Environmental Medicine, University Medicine, Greifswald, Germany
2 Institute of Immunology and Transfusion Medicine, University Medicine, Greifswald, Germany
3 ZIK plasmatis, Leibniz Institute for Plasma Science and Technology (INP), Greifswald, Germany
4 Unit of Periodontology, Dental School, University Medicine, Greifswald, Germany
Zusammenfassung
Problemstellung: Physikalisches Plasma ist eine neue, vielversprechende Möglichkeit zur Inaktivierung von Mikroorganismen insbesondere in Hinblick auf die Antiseptik chronischer infizierter Wunden. Plasma kann in verschiedenen Trägergasen generiert und verschiedenartig appliziert werden, woraus unterschiedliche biologische Effekte resultieren. Ein Screening verschiedener Gasmischungen und Applikationsformen ist daher erforderlich, um geeignete Gasmischungen zur antimikrobiellen Behandlung mit Plasma zu ermitteln und neue Erkenntnisse für geeignete Behandlungsstrategien zu erhalten.
Methode: Es wurde ein Hochfrequenz-Plasmajet, der gewebeverträgliches Plasma (Tissue Tolerable Plasma, TTP) erzeugt, verwendet, um die antimikrobielle Wirksamkeit von Plasma in Argon und Helium ohne und mit Beimischung von 0,1%, 0,5% und 1% Sauerstoff und in Luft an den Testorganismen Pseudomonas aeruginosa (P. aeruginosa) und Staphylococcus aureus (S. aureus) zu vergleichen. Die Applikationen erfolgten je in einem zur Umgebungsatmosphäre offenen bzw. geschlossenen System. Die Bakterien wurden auf Nähragar ausplattiert und punktförmig mit Plasma behandelt. Zur Wirksamkeitsbestimmung wurden Wachstums-Hemmhöfe ausgemessen und mittels Anzahl der koloniebildenden Einheiten (KbE) auf der Platte der Reduktionsfaktor bestimmt.
Ergebnisse: Bei S. aureus und P. aeruginosa wurden sowohl Hemmhöfe als auch Gesamtreduktionen beobachtet, wobei es bei S. aureus verstärkt zu einer Gesamtreduktion kam. Am Merkmal der Hemmhöfe zeigte Argonplasma mit 0,1% Sauerstoff den stärksten antimikrobiellen Effekt an beiden Spezies. S. aureus war gegenüber Plasmabehandlungen mit Helium mit >0,1% Sauerstoff sensibler als P. aeruginosa, während P. aeruginosa sensibler nach Plasmabehandlungen mit Argon und Argon mit Sauerstoffbeimischungen reagierte. Luftplasma zeigte im Vergleich zu den anderen Trägergasen einen sehr geringen antimikrobiellen Effekt. Behandlung im geschlossenen System verstärkte die Plasmawirkung in den meisten Fällen. Die Intensität des Plasmaeffekts unterschied sich in Abhängigkeit von der Anwendungsdauer und der Gaszusammensetzung.
Diskussion: Erwartungsgemäß wurde in den meisten Fällen die Wirksamkeit des Plasmas bei steigender Sauerstoffbeimischung verstärkt. Die unterschiedlichen Plasmaeffekte der verschiedenen Gasmischungen können auf Grund der Generierung unterschiedlicher reaktiver Sauerstoffspezies oder energiereicher Strahlung vermutet werden.
Schlussfolgerung: Im Hinblick auf medizinische Anwendungen zur Wundbehandlung und Antiseptik multiresistenter Erreger verstärkt ein geschlossenes Behandlungssystem die antiseptische Wirkung von Plasma und könnte neue Wege zur Anwendung von TTP öffnen.
Introduction
Contaminated implants, indwelling devices, or the colonization of wounds are often associated with microbial infections [1], [2]. For treatment of chronic infected wounds and for decontamination of indwelling devices as well as implants the antimicrobial plasma effect could be an interesting alternative to current methods or supplemental to chemical antimicrobial therapies that are limited by microorganism drug resistance or toxicity [3], [4].
Physical plasma is characterized by enriched, free charge carriers in a gas (ions, electrons) and their secondary reactive products [5]. The main antimicrobial mechanisms of plasma discussed are reactive oxygen species (ROS), reactive nitrogen species (RNS), and partly UV radiation [6]. New plasma sources were constructed for the usage of plasma in an atmospheric environment at low temperature [7], [8]. This allows plasma application in atmospheric conditions without the hazard of burn injuries on tissues [9]. These properties promote plasma treatment in medical applications. The carrier gases used for generating plasma are mainly argon, helium, compressed-air, and variations with oxygen and nitrogen admixtures. Plasma chemistry and resulting biological effects vary in dependency on the carrier gas used [10]. Determining specific effects or differences between the gas mixtures could help to find the plasma parameters best suitable for highly efficient antimicrobial effects. Equally, the setup plasma generation modulates its effects on cells and tissue. In the present study, we used a radio-frequency plasma jet (kinpen® 09) [11] which is a tissue tolerable plasma source (TTP) in limited doses [12], [13]. Argon or helium alone, or with 0.1%, 0.5%, 1% oxygen, or air as carrier gas were compared with each other by the microorganism-agar test (MAT) [14]. Plasma was applied in either an open or a delimited system. The test organisms were Pseudomonas aeruginosa and Staphylococcus aureus. Both are opportunistic pathogens that are frequently involved in chronic infections or indwelling device associated infections [15] and often exhibit multiple drug resistance [16], [17], [18]. Increasing the oxygen fraction to the carrier gas was expected to be accompanied by elevated levels of ROS and therefore a rising antimicrobial effects. Application of a delimited system minimizes interference with indoor-air and accumulates plasma products under the cover plate possibly increasing the antimicrobial effect.
Methods
Bacterial preparation and analyses
Two bacterial strains were tested: Gram-negative Pseudomonas aeruginosa SG81 (P. aeruginosa) and Gram-positive Staphylococcus aureus ATCC 6538 (S. aureus). Bacteria were cultured on blood agar plates (Columbia Agar +5% sheep blood, bioMérieux, Nürtingen, Germany) and prepared for the test according to methods described before [14]. Colonies were rinsed off the plate and washed 3 times with phosphate buffered saline solution (PBS) by centrifugation at 3,300 g for 15 min. Pellets were resuspended in 10 ml of PBS and a serial dilution was prepared to yield a suspension of 105 cells/ml. Then, 100 µl were spread onto blood-agar and incubated for 20 min at room temperature.
After plasma treatment, agar plates were incubated for 24 h at 37°C. Then, the diameter of the inhibition zones (IZ) was measured and the colony forming units (CFU) were determined by counting of each colony if an overall reduction (OR) compared to untreated control and without an IZ was observable (examples are shown in Figure 1 [Fig. 1]). Means of the measured or counted values were calculated. The reduction factor (RF) was determined by subtracting the CFU of controls (untreated samples) and CFU of treated samples in log10.
Figure 1: From left to right, examples of agar plates with grown colonies of Staphylococcus aureus: untreated control, very centred inhibition zone (Ar + 0.1% O2, 120 s exposure time in closed system, spatial-intermediate inhibition (Ar + 0.5% O2, 60 s exposure time in open system), un-centric overall reduction (Ar + 1% O2, 120 s exposure time in open system).
Plasma application
A radio-frequency atmospheric pressure plasma jet (kinpen® 09, neoplastools, Greifswald, Germany) developed by the Leibnitz Institute for Plasma Science and Technology (INP) was used. Technical details have been described in detail elsewhere [11]. The pen was fixed 10 mm above the prepared petri dishes. The exposure time was 10, 30, 60, and 120 s each opened (open system) or delimited (closed system) to the environment. In order to implement the closed system, a hole (Ø 3 mm) was drilled in petri dish covers that laid on the prepared petri dishes. Through this hole the plasma plume reached the sample (Figure 2 [Fig. 2]). Petri dishes had ventilation cams, so that the accumulated gas escaped at the border. For the parameters used the heat output was 320 mW (calorimetric measurement). Argon (Ar) and argon admixed with 0.1%, 0.5%, and 1% oxygen (Ar + 1% O2, Ar + 0.5% O2, Ar + 1% O2), helium (He), helium admixed with 0.1%, 0.5%, and 1% oxygen (He + 0.1% O2, He + 0.5% O2, He + 1% O2), and compressed air were used as carrier gas with a gas flow rate of 5 standard l/min (slm). The gas flow was controlled by a mass flow controller (MKS Instruments, Munich, Germany). As negative control each respective gas (without plasma) and for experimental control untreated samples were used. All experiments were performed two times.
Figure 2: Left, setup for the closed system with a hole in the petri dish cover plate; right, setup for the opened system
Spectrometric measurement
Excited oxygen (777 nm), hydroxyl (308 nm) and nitrogen (316, 337 and 357 nm) was measured by Avantes AvaSpec-3648 (Apeldoorn, Netherlands) in the same distance of 10 mm like the plasma application on bacteria.
Results
The plasma effects varied depending on the carrier gas used, the system setup, and the bacterial strain. Inhibition zone or general CFU reduction was observable. The results differ between S. aureus (Table 1 [Tab. 1]) and P. aeruginosa (Table 2 [Tab. 2]). The largest IZ was observed after Ar + 0.1% O2 plasma for P. aeruginosa and S. aureus in a closed system. The highest RF for S. aureus of approximately 2 log10 was shown for Ar + 1% O2 in the closed system. For P. aeruginosa, an overall reduction (1.4 log10) was shown only once after 120 s plasma treatment in the closed system. The lowest antimicrobial effect for both organisms showed He-plasmas and air plasma. No effect was shown on S. aureus after treatment with He and He + 0.1% oxygen plasma.
Table 1: Inhibition of Staphylococcus aureus ATCC 6538 after application of argon (Ar) or helium (He) alone, Ar or He admixed with 0.1%, 0.5%, or 1% O2, and air plasma for 10–120 s treatment time in an opened or closed system. The diameter of inhibition zone (IZ) was measured in mm, the overall reduction (OR) was calculated as reduction rate of colonies in log10 (lg). No entry if no effect (NE) was observable or evaluable.
Table 2: Inhibition of Pseudomonas aeruginosa SG81 after application of argon (Ar) or helium (He) alone, Ar or He admixed with 0.1%, 0.5% or 1% O2, and air plasma for 10–120 s treatment time in an opened or closed system. The diameter of inhibition zone (IZ) was measured in mm, the overall reduction (OR) was calculated as reduction rate of colonies in log10 (lg). No entry if no effect (NE) was observable or was not evaluable.
Compared to treatment in the open system, antimicrobial effects were always more effective for Ar and Ar + O2 plasma, as well as He admixed with ≥0.5% oxygen plasma against both species in the closed system. No antimicrobial effect was shown for P. aeruginosa after treatment with He and He + 0.1% O2 in closed systems. In an open system on the other hand, IZs of approximately 5 mm were shown after 120 s plasma treatment. For S. aureus after 60 s of Ar + 0.5% O2 plasma treatment, the image of spatial reduction changed from local to overall at 0.4 log10 in the open system (Figure 1 [Fig. 1]).
He plasma with admixed oxygen <0.5% for S. aureus in the open system showed no antimicrobial effect but by increasing oxygen concentration >0.5% the IZ measured was up to 45 mm (60 s, He + 1% O2 plasma, closed system) and resulted into a total reduction after prolonged treatment times.
Air plasma was antimicrobially effective only after 120 s plasma treatment for S. aureus in an open and more effectively in a closed system with 1.1 log10. For P. aeruginosa an IZ of 5 mm was shown only in a closed system.
Discussion
Plasma applications for medical use are of increasing importance [19]. Depending on the source they differ in chemico-physical properties. Plasma chemistry generated varies due to differences in plasma ignition and is additionally influenced by environmental conditions resulting in different biological effects. Coevally, bacterial strains are differently sensitive to different types of plasma. Argon, helium, and air are often used gases for plasma generation under atmospheric conditions [5].
This study investigated the efficacy of different carrier gases for plasma generation by MAT. The MAT is a suitable method to screen plasma sources by their antimicrobial effects [14]. Two different setups were investigated. The plasma was used in an open system – the plasma plume distributed in and interacted with the environmental atmosphere – and a closed system – the plasma exhaust accumulated inside of the petri dish.
Generally, the efficacy for argon and helium with <0.5% oxygen plasma is similar for both organisms. P. aeruginosa was more sensitive for argon and argon admixed with oxygen plasma compared to S. aureus while S. aureus was more sensitive to helium with ≥0.5% oxygen plasma. As expected, the antimicrobial action of argon and helium increased by admixture of increasing concentrations of oxygen plasma for both organisms in a closed system. Interestingly, the phenomena of changing effects from IZ to OR after oxygen supplementation were predominantly observed for S. aureus. This antimicrobial variation may be due to complex radical kinetics or because of altered amounts of a certain reactive species as a result of admixed oxygen. To undermine this hypothesis, the amount of excited oxygen was measured. Interestingly, the highest level was found at 0.1% and the lowest at 1% oxygen admixture. Comparable results were shown after admixture of oxygen in He plasma (excited hydroxyl scarcely detectable) while in air plasma only excited N2 was detectable. This could partly explain the low antimicrobial effect of air plasma.
Interaction of plasma with the nutrient agar can be excluded by pre-tests since plasma treated agar plates showed differences in growth to the untreated control.
The discrimination between IZ and OR seem to be governed by the amount of oxygen admixed and the total treatment time.
Each negative control with the carrier gases alone showed no antimicrobial effects. Hence, drying or toxic effects of the pure carrier gas on the organisms can be foreclosed.
Open and closed plasma application was compared against each other because different treatment surfaces demand for different plasma applications. Up to now, it is difficult to treat uneven or highly structured surfaces with TTP homogenously since plasma jets allow only a punctiform treatment. Although surface barrier discharged plasma sources circumvent this problem they require a very short distance to the target and need an even surface to be effective. The results of this study show that a capsule (closed system) combined with a carrier gas admixtured with oxygen enhances the antimicrobial efficacy in vitro.
This knowledge could be helpful for TTP treatment of open wounds and antisepsis. The investigated S. aureus is often involved in chronic wounds [20]. A recent study of TTP treatments showed that the antimicrobial efficacy against different S. aureus strains is constant and independent of drug resistant [21].
Using air plasma would be much more convenient in clinical settings by eliminating the need to supply industry gases but here the plasma and radical generation has to become more powerful for an efficient antiseptic effect.
Conclusions
The highest antimicrobial effect was shown for argon plasma and argon admixed with oxygen plasma. Admixing ≥0.5% oxygen reduces the antimicrobial plasma effect of IZ but promotes a change of a small local plasma effect to an effect covering the whole agar surface. The differences in bacterial growth inhibition of the used strains show that it is not possible to determine one general antimicrobial component-mixture in plasma for every bacterial genus.
Notes
Acknowledgements
This work was realized as part of the multidisciplinary cooperative research project ‘Campus PlasmaMed’ within the program ‘PlasmaCure’. The authors thank Jaqueline Mentz for her excellent technical assistance and René Bussiahn for his introduction and analysis of spectrometric data. This work was supported by a grant from the German Ministry of Education and Research (BMBF, grant No. 13N9779).
Competing interests
The authors declare that they have no competing interests.
References
[1] Braxton EE Jr, Ehrlich GD, Hall-Stoodley L, Stoodley P, Veeh R, Fux C, Hu FZ, Quigley M, Post JC. Role of biofilms in neurosurgical device-related infections. Neurosurg Rev. 2005 Oct;28(4):249-55. DOI: 10.1007/s10143-005-0403-8[2] Edwards R, Harding KG. Bacteria and wound healing. Curr Opin Infect Dis. 2004 Apr;17(2):91-6. DOI: 10.1097/00001432-200404000-00004
[3] Percival SL, Bowler PG. Biofilms and their potential role in wound healing. Wounds. 2004;16(7):234-40. Available from: http://www.woundsresearch.com/article/2870
[4] Marquardt C, Matuschek E, Bölke E, Gerber PA, Peiper M, V Seydlitz-Kurzbach J, Buhren BA, van Griensven M, Budach W, Hassan M, Kukova G, Mota R, Höfer D, Orth K, Fleischmann W. Evaluation of the tissue toxicity of antiseptics by the hen's egg test on the chorioallantoic membrane (HETCAM). Eur J Med Res. 2010 May 18;15(5):204-9. Available from: http://www.eurjmedres.com/content/15/5/204
[5] Morfill GE, Kong MG, Zimmermann JL. Focus on Plasma Medicine. New J. Phys. 2009;11(11):115011. DOI: 10.1088/1367-2630/11/11/115011
[6] Nosenko T, Shimizu T, Morfill GE. Designing plasmas for chronic wound disinfection. New J Phys. 2009;11:115013. DOI: 10.1088/1367-2630/11/11/115013
[7] Kong MG, Kroesen G, Morfill G, Nosenko T, Shimizu T, van Dijk J, Zimmermann JL. Plasma medicine: an introductory review. New J Phys. 2009;11:115012. DOI: 10.1088/1367-2630/11/11/115012
[8] Weltmann KD, Kindel E, von Woedtke T, Hähnel M, Stieber M, Brandenburg R. Atmospheric-pressure plasma sources: Prospective tools for plasma medicine. Pure Appl Chem. 2010;82(6):1223-37. DOI: 10.1351/Pac-Con-09-10-35
[9] Lademann O, Richter H, Patzelt A, Alborova A, Humme D, Weltmann K-D, Hartmann B, Hinz P, Kramer A, Koch S. Application of a plasma-jet for skin antisepsis: analysis of the thermal action of the plasma by laser scanning microscopy. Laser Physics Letters. 2010;7(6):458-62. DOI: 10.1002/lapl.200910158
[10] Dobrynin D, Fridman G, Friedman G, Fridman A. Physical and biological mechanisms of direct plasma interaction with living tissue. New J Phys. 2009;11. DOI: 10.1088/1367-2630/11/11/115020
[11] Weltmann KD, Kindel E, Brandenburg R, Meyer C, Bussiahn R, Wilke C, von Woedtke T. Atmospheric Pressure Plasma Jet for Medical Therapy: Plasma Parameters and Risk Estimation Contrib Plasma Phys. 2009;49(9):631-40. DOI: 10.1002/ctpp.200910067
[12] Hammann A, Huebner NO, Bender C, Ekkernkamp A, Hartmann B, Hinz P, Kindel E, Koban I, Koch S, Kohlmann T, Lademann J, Matthes R, Müller G, Titze R, Weltmann KD, Kramer A. Antiseptic efficacy and tolerance of tissue-tolerable plasma compared with two wound antiseptics on artificially bacterially contaminated eyes from commercially slaughtered pigs. Skin Pharmacol Physiol. 2010;23(6):328-32. DOI: 10.1159/000314724
[13] Lademann O, Kramer A, Richter H, Patzelt A, Meinke MC, Czaika V, Weltmann KD, Hartmann B, Koch S. Skin disinfection by plasma-tissue interaction: comparison of the effectivity of tissue-tolerable plasma and a standard antiseptic. Skin Pharmacol Physiol. 2011;24(5):284-8. DOI: 10.1159/000329913
[14] Matthes R, Hübner N-O, Bender C, Koban I, Weltmann K-D, Kramer A. Screening test for quality control of surface barrier discharged plasma sources with the microorganism-agar test (MAT). GMS Krankenhaushyg Interdiszip. 2010;5(2):Doc02. DOI: 10.3205/dgkh000145
[15] Burmølle M, Thomsen TR, Fazli M, Dige I, Christensen L, Homøe P, Tvede M, Nyvad B, Tolker-Nielsen T, Givskov M, Moser C, Kirketerp-Møller K, Johansen HK, Høiby N, Jensen PØ, Sørensen SJ, Bjarnsholt T. Biofilms in chronic infections – a matter of opportunity – monospecies biofilms in multispecies infections. FEMS Immunol Med Microbiol. 2010 Aug;59(3):324-36. DOI: 10.1111/j.1574-695X.2010.00714.x
[16] Costerton JW, Stewart PS, Greenberg EP. Bacterial biofilms: a common cause of persistent infections. Science. 1999 May 21;284(5418):1318-22. DOI: 10.1126/science.284.5418.1318
[17] Uçkay I, Pittet D, Vaudaux P, Sax H, Lew D, Waldvogel F. Foreign body infections due to Staphylococcus epidermidis. Ann Med. 2009;41(2):109-19. DOI: 10.1080/07853890802337045
[18] Schaber JA, Triffo WJ, Suh SJ, Oliver JW, Hastert MC, Griswold JA, Auer M, Hamood AN, Rumbaugh KP. Pseudomonas aeruginosa forms biofilms in acute infection independent of cell-to-cell signaling. Infect Immun. 2007 Aug;75(8):3715-21. DOI: 10.1128/IAI.00586-07
[19] Kramer A, Hübner N, Assadian O, Below H, Bender C, Benkhai H, Bröker B, Ekkernkamp A, Eisenbeiß W, Hammann A, Hartmann B, Heidecke C-D, Hinz P, Koban I, Koch S, Kocher T, Lademann J, Lademann O, Lerch M, Maier S, Matthes R, Müller G, Partecke I, Rändler C, Weltmann K-D, Zygmunt M. Chancen und Perspektiven der Plasmamedizin durch Anwendung von gewebekompatiblen Atmosphärendruckplasmen (Tissue Tolerable Plasmas, TTP) [Chances and perspectives of the plasma medicine by use of Tissue Tolerable Plasma (TTP)]. GMS Krankenhaushyg Interdiszip. 2009;4 (2)Doc10:1-15. DOI: 10.3205/dgkh000135
[20] Dissemond J, Schmid EN, Esser S, Witthoff M, Goos M. Bakterielle Kolonisation chronischer Wunden. Untersuchungen in einer universitaren dermatologischen Wundambulanz unter besonderer Berucksichtigung von ORSA [Bacterial colonization of chronic wounds. Studies on outpatients in a university dermatology clinic with special consideration of ORSA]. Hautarzt. 2004 Mar;55(3):280-8. DOI: 10.1007/s00105-004-0697-4
[21] Hübner N, Matthes R, et al. Antimicrobial efficacy of low-temperature plasma against 65 genetically characterized Staphylococcus aureus isolates including PVL-positive, MRS aureus and c-MRS aureus strains. In: International Conference on Antimicrobial Research (ICAR2010); 2010; Valladolid, Spain.



